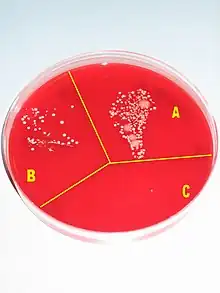

Hand washing
Hand washing (or handwashing), also known as hand hygiene, is the act of cleaning one's hands with soap or handwash and water to remove viruses/bacteria/microorganisms, dirt, grease, or other harmful and unwanted substances stuck to the hands. Drying of the washed hands is part of the process as wet and moist hands are more easily recontaminated.[1][2] If soap and water are unavailable, hand sanitizer that is at least 60% (v/v) alcohol in water can be used as long as hands are not visibly excessively dirty or greasy.[3][4] Hand hygiene is central to preventing the spread of infectious diseases in home and everyday life settings.[5]
| Hand washing | |
|---|---|
![]() Hand washing with soap and water at a sink | |
| Other names | Handwashing, hand hygiene |
The World Health Organization (WHO) recommends washing hands for at least 20 seconds before and after certain activities.[6][7] These include the five critical times during the day where washing hands with soap is important to reduce fecal-oral transmission of disease: after using the toilet (for urination, defecation, menstrual hygiene), after cleaning a child's bottom (changing diapers), before feeding a child, before eating and before/after preparing food or handling raw meat, fish, or poultry.[8]
When both hand washing and using hand sanitizer are not available, hands can be cleaned with uncontaminated ash and clean water, although the benefits and harms are uncertain for reducing the spread of viral or bacterial infections.[9] However, frequent hand washing can lead to skin damage due to drying of the skin.[10] Moisturizing lotion is often recommended to keep the hands from drying out; dry skin can lead to skin damage which can increase the risk for the transmission of infection.[11]
Steps and duration

The United States Centers for Disease Control and Prevention (CDC) recommends the following steps when washing one's hands for the prevention of transmission of disease:[12]
- Wet hands with warm or cold running water.[12] Running water is recommended because standing basins may be contaminated, while the temperature of the water does not seem to make a difference, however some experts suggest warm, tepid water may be superior.[1]
- Lather hands by rubbing them with a generous amount of soap, including the backs of hands, between fingers, and under nails.[12] Soap lifts pathogens from the skin, and studies show that people tend to wash their hands more thoroughly when soap is used rather than water alone.[1]
- Scrub for at least 20 seconds.[12] Scrubbing creates friction, which helps remove pathogens from skin, and scrubbing for longer periods removes more pathogens.[1]
- Rinse well under running water.[12] Rinsing in a basin can recontaminate hands.[1]
- Dry with a clean towel or allow to air dry.[12] Wet and moist hands are more easily recontaminated.[1]
The most commonly missed areas are the thumb, the wrist, the areas between the fingers, and under fingernails. Artificial nails and chipped nail polish may harbor microorganisms.[11]
When it is recommended
There are five critical times during the day where washing hands with soap is important to reduce fecal-oral transmission of disease: after using the toilet (for urination, defecation, menstrual hygiene), after cleaning a child's bottom (changing diapers), before feeding a child, before eating and before/after preparing food or handling raw meat, fish, or poultry.[8] Other occasions when correct handwashing technique should be practiced in order to prevent the transmission of disease include before and after treating a cut or wound; after sneezing, coughing, or blowing your nose; after touching animal waste or handling animals; and after touching garbage.[13][14]
Public health
Health benefits

Hand washing has many significant health benefits, including minimizing the spread of influenza, COVID-19, and other infectious diseases;[15][16] preventing infectious causes of diarrhea;[17] decreasing respiratory infections;[18] and reducing infant mortality rate at home birth deliveries.[19] A 2013 study showed that improved hand washing practices may lead to small improvements in the length growth in children under five years of age.[20] In developing countries, childhood mortality rates related to respiratory and diarrheal diseases can be reduced by introducing simple behavioral changes, such as hand washing with soap. This simple action can reduce the rate of mortality from these diseases by almost 50%.[21] Interventions that promote hand washing can reduce diarrhoea episodes by about a third, and this is comparable to providing clean water in low income areas.[22] 48% of reductions in diarrhoea episodes can be associated with hand washing with soap.[23]
Handwashing with soap is the single most effective and inexpensive way to prevent diarrhea and acute respiratory infections (ARI), as automatic behavior performed in homes, schools, and communities worldwide. Pneumonia, a major ARI, is the number one cause of mortality among children under five years old, taking the lives of an estimated 1.8 million children per year. Diarrhea and pneumonia together account for almost 3.5 million child deaths annually.[24] According to UNICEF, turning handwashing with soap before eating and after using the toilet into an ingrained habit can save more lives than any single vaccine or medical intervention, cutting deaths from diarrhea by almost half and deaths from acute respiratory infections by one-quarter. Hand washing is usually integrated with other sanitation interventions as part of water, sanitation, and hygiene (WASH) programmes. Hand washing also protects against impetigo which is transmitted through direct physical contact.[25]
Adverse effects
A small detrimental effect of handwashing is that frequent hand washing can lead to skin damage due to the drying of the skin.[10] A 2012 Danish study found that excessive hand washing can lead to an itchy, flaky skin condition known as contact dermatitis, which is especially common among health-care workers.[26]
Behavior change

In many countries, there is a low rate of hand washing with soap. A study of hand washing in 54 countries in 2015 found that on average, 38.7% of households practiced hand washing with soap.[27]
A 2014 study showed that Saudi Arabia had the highest rate of 97%; the United States near the middle with 77%; and China with the lowest rate of 23%.[28]
Several behavior change methodologies now exist to increase uptake of the behavior of hand washing with soap at the critical times.[29][30]
Group hand washing for school children at set times of the day is one option in developing countries to engrain hand washing in children's behaviors.[31] The "Essential Health Care Program" implemented by the Department of Education in the Philippines is an example of at scale action to promote children's health and education.[32] Deworming twice a year, supplemented with washing hands daily with soap, brushing teeth daily with fluoride, is at the core of this national program. It has also been successfully implemented in Indonesia.[33]
Substances used
Soap and detergents
Removal of microorganisms from skin is enhanced by the addition of soaps or detergents to water.[34] Soap and detergents are surfactants that kill microorganisms by disorganizing their membrane lipid bilayer and denaturing their proteins. It also emulsifies oils, enabling them to be carried away by running water.[35]
Solid soap
Solid soap, because of its reusable nature, may hold bacteria acquired from previous uses.[36] A small number of studies which have looked at the bacterial transfer from contaminated solid soap have concluded transfer is unlikely as the bacteria are rinsed off with the foam.[37] The CDC still states "liquid soap with hands-free controls for dispensing is preferable".[38]
Antibacterial soap
Antibacterial soaps have been heavily promoted to a health-conscious public. To date, there is no evidence that using recommended antiseptics or disinfectants selects for antibiotic-resistant organisms in nature.[39] However, antibacterial soaps contain common antibacterial agents such as triclosan, which has an extensive list of resistant strains of organisms. So, even if antibiotic resistant strains are not selected for by antibacterial soaps, they might not be as effective as they are marketed to be. Besides the surfactant and skin-protecting agent, the sophisticated formulations may contain acids (acetic acid, ascorbic acid, lactic acid) as pH regulator, antimicrobially active benzoic acid and further skin conditioners (aloe vera, vitamins, menthol, plant extracts).[40]
A 2007 meta-analysis from the University of Oregon School of Public Health indicated that plain soaps are as effective as consumer-grade anti-bacterial soaps containing triclosan in preventing illness and removing bacteria from the hands.[41] Dissenting, a 2011 meta-analysis in the Journal of Food Protection argued that when properly formulated, triclosan can grant a small but detectable improvement, as can chlorhexidine gluconate, iodophor, or povidone.[42][43]
Warm water
Hot water that is still comfortable for washing hands is not hot enough to kill bacteria. Bacteria grow much faster at body temperature (37 °C). WHO considers warm soapy water to be more effective than cold, soapy water at removing natural oils which hold soils and bacteria.[44] But CDC mentions that warm water causes skin irritations more often and its ecological footprint is more significant.[1] Water temperatures from 4 to 40 °C do not differ significantly regarding removal of microbes. The most important factor is proper scrubbing.[45]
Contrary to popular belief, scientific studies have shown that using warm water has no effect on reducing the microbial load on hands.[45][46] Using hot water for handwashing can even be regarded as a waste of energy.[47]
Antiseptics (hand sanitizer)

In situations where hand washing with soap is not an option (e.g., when in a public place with no access to wash facilities), a water less hand sanitizer such as an alcohol hand gel can be used. They can be used in addition to hand washing to minimize risks when caring for "at-risk" groups. To be effective, alcohol hand gels should contain not less than 60%v/v alcohol. Enough hand antiseptic or alcohol rub must be used to thoroughly wet or cover both hands. The front and back of both hands and between and the ends of all fingers must be rubbed for approximately 30 seconds until the liquid, foam or gel is dry. Finger tips must be washed well too, rubbing them in both palms.[48]
A hand sanitizer or hand antiseptic is a non-water-based hand hygiene agent. In the late 1990s and early part of the 21st century, alcohol rub non-water-based hand hygiene agents (also known as alcohol-based hand rubs, antiseptic hand rubs, or hand sanitizers) began to gain popularity. Most are based on isopropyl alcohol or ethanol formulated together with a thickening agent such as Carbomer (polymer of acrylic acid) into a gel, or a humectant such as glycerin into a liquid, or foam for ease of use and to decrease the drying effect of the alcohol.[49] Adding diluted hydrogen peroxide increases further the antimicrobial activity.[50]
Hand sanitizers are most effective against bacteria and less effective against some viruses. Alcohol-based hand sanitizers are almost entirely ineffective against norovirus (or Norwalk) type viruses, the most common cause of contagious gastroenteritis.[51]
US Centers for Disease Control and Prevention recommend hand washing with soap over hand sanitizer rubs, particularly when hands are visibly dirty.[52] The increasing use of these agents is based on their ease of use and rapid killing activity against micro-organisms; however, they should not serve as a replacement for proper hand washing unless soap and water are unavailable. Despite their effectiveness, non-water agents do not cleanse the hands of organic material, but simply disinfect them. It is for this reason that hand sanitizers are not as effective as soap and water at preventing the spread of many pathogens, since the pathogens remain on the hands.
Wipes
Hand washing using hand sanitizing wipes is an alternative during traveling in the absence of soap and water.[53] Alcohol-based hand sanitizer should contain at least 60% alcohol.[54]
Ash or mud
Many people in low-income communities cannot afford soap and use ash or soil instead. The World Health Organization recommended ash or sand as an alternative to soap when soap is not available.[55] Use of ash is common in rural areas of developing countries and has in experiments been shown at least as effective as soap for removing pathogens.[56] However, evidence to support the use of ash to wash hands is of poor quality. It is not clear if washing hands with ash is effective at reducing viral or bacterial spreading compared to washing with mud, not washing, or with washing with water alone.[9] One concern is that if the soil or ash is contaminated with microorganisms it may increase the spread of disease rather than decrease it,[57] however, there is also no clear evidence to determine the level of risk.[9] Like soap, ash is also a disinfecting agent because in contact with water, it forms an alkaline solution.[58]
Technologies and design aspects
Low-cost options when water is scarce

Various low-cost options can be made to facilitate hand washing where tap-water and/or soap is not available e.g. pouring water from a hanging jerrycan or gourd with suitable holes and/or using ash if needed in developing countries.[59]
In situations with limited water supply (such as schools or rural areas in developing countries), there are water-conserving solutions, such as "tippy-taps" and other low-cost options.[60] A tippy-tap is a simple technology using a jug suspended by a rope, and a foot-operated lever to pour a small amount of water over the hands and a bar of soap.[61]
Low-cost hand washing technologies for households may differ from facilities for multiple users.[62] For households, options include tippy taps, bucket/container with tap (such as a Veronica Bucket), conventional tap with/without basin, valve/tap fitted to bottles, bucket and cup, camp sink.[62] Options for multiple users include: adapting household technologies for multiple users, water container fitted to a pipe with multiple taps, water container fitted to a pipe with holes.[62]
Advanced technologies
Several companies around the globe have developed technologies that aim to improve the hand washing process. Among the different inventions, there are eco-friendly devices that use 90% less water and 60% less soap compared to hand washing under a faucet.[63][64] Another device uses light-based rays to detect contaminants on the hands after they have been washed.[65]
Certain environments are especially sensitive to the transmission of pathogenic microorganisms, like health care and food production. Organizations attempting to prevent infection transmission in these environments have started using programmed washing cycles that provide sufficient time for scrubbing the hands with soap and rinsing them with water. Combined with AI-powered software, these technological advancements turn the hand-washing process into digital data, allowing individuals to receive insights and improve their hand hygiene practices.[66][67][68]

Drying with towels or hand driers
Effective drying of the hands is an essential part of the hand hygiene process. Therefore, the proper drying of hands after washing should be an integral part of the hand hygiene process in health care.[2]
The World Health Organization (WHO) and the Centers for Disease Control and Prevention (CDC) are clear and straightforward concerning hand hygiene, and recommend paper towels and hand dryers equally. Both have stressed the importance of frequent and thorough hand washing followed by their complete drying as a means to stop the spread of pathogens, like COVID-19. Specifically, the World Health Organization recommends that everyone "frequently clean [their] hands..." and "dry [them] thoroughly by using paper towels or a warm air dryer." The CDC report that, "Both [clean towels or air hand dryers] are effective ways to dry hands."
A study in 2020 found that hand dryers and paper towels were both found to be equally hygienic hand-drying solutions.[69]
However, there is some debate over the most effective form of drying in public toilets. A growing volume of research suggests paper towels are much more hygienic than the electric hand dryers found in many public toilets. A review in 2012 concluded that "From a hygiene standpoint, paper towels are superior to air dryers; therefore, paper towels should be recommended for use in locations in which hygiene is paramount, such as hospitals and clinics."[2]
Jet-air dryers were found to be capable of blowing micro-organisms from the hands and the unit and potentially contaminating other users and the environment up to 2 metres (6.6 feet) away.[70] In the same study in 2008 (sponsored by the paper-towel industry the European Tissue Symposium), use of a warm-air hand dryer spread micro-organisms only up to 0.25 metres (0.82 feet) from the dryer, and paper towels showed no significant spread of micro-organisms. No studies have found a correlation to hand dryers and human health, however, making these findings inconsequential.
Accessibility

Making hand washing facilities accessible (inclusive) to everyone is crucial to maintain hand washing behavior.[62]: 27 Considerations for accessibility include age, disability, seasonality (with rains and muddiness), location and more. Important aspects for good accessibility include: Placement of the technology, paths, ramps, steps, type of tap, soap placement.[62]: 27
Medical use
Medical hand-washing became mandatory long after Hungarian physician Ignaz Semmelweis discovered its effectiveness (in 1846) in preventing disease in a hospital environment.[71] There are electronic devices that provide feedback to remind hospital staff to wash their hands when they forget.[72] One study has found decreased infection rates with their use.[73]
Method
Medical hand-washing is for a minimum of 15 seconds, using generous amounts of soap and water or gel to lather and rub each part of the hands.[74] Hands should be rubbed together with digits interlocking. If there is debris under fingernails, a bristle brush may be used to remove it. Since pathogens may remain in the water on the hands, it is important to rinse well and wipe dry with a clean towel.[75] After drying, the paper towel should be used to turn off the water (and open any exit door if necessary). This avoids re-contaminating the hands from those surfaces.
The purpose of hand-washing in the health-care setting is to remove pathogenic microorganisms ("germs") and avoid transmitting them. The New England Journal of Medicine reports that a lack of hand-washing remains at unacceptable levels in most medical environments, with large numbers of doctors and nurses routinely forgetting to wash their hands before touching patients, thus transmitting microorganisms.[76] One study showed that proper hand-washing and other simple procedures can decrease the rate of catheter-related bloodstream infections by 66%.[77]
The World Health Organization has published a sheet demonstrating standard hand-washing and hand-rubbing in health-care sectors.[78] The draft guidance of hand hygiene by the organization can also be found at its website for public comment.[44] A relevant review was conducted by Whitby et al.[79] Commercial devices can measure and validate hand hygiene, if demonstration of regulatory compliance is required.
The World Health Organization has "Five Moments" for washing hands:
- before patient care
- after environmental contact
- after exposure to blood/body fluids
- before an aseptic task, and
- after patient care.
The addition of antiseptic chemicals to soap ("medicated" or "antimicrobial" soaps) confers killing action to a hand-washing agent. Such killing action may be desired before performing surgery or in settings in which antibiotic-resistant organisms are highly prevalent.[80]
To 'scrub' one's hands for a surgical operation, it is necessary to have a tap that can be turned on and off without touching it with the hands, some chlorhexidine or iodine wash, sterile towels for drying the hands after washing, and a sterile brush for scrubbing and another sterile instrument for cleaning under the fingernails. All jewelry should be removed. This procedure requires washing the hands and forearms up to the elbow, usually 2–6 minutes. Long scrub-times (10 minutes) are not necessary. When rinsing, water on the forearms must be prevented from running back to the hands. After hand-washing is completed, the hands are dried with a sterile cloth and a surgical gown is donned.
Effectiveness in healthcare settings
To reduce the spread of pathogens, it is better to wash the hands or use a hand antiseptic before and after tending to a sick person.
For control of staphylococcal infections in hospitals, it has been found that the greatest benefit from hand-cleansing came from the first 20% of washing, and that very little additional benefit was gained when hand cleansing frequency was increased beyond 35%.[81] Washing with plain soap results in more than triple the rate of bacterial infectious disease transmitted to food as compared to washing with antibacterial soap.[82]
Comparing hand-rubbing with alcohol-based solution with hand washing with antibacterial soap for a median time of 30 seconds each showed that the alcohol hand-rubbing reduced bacterial contamination 26% more than the antibacterial soap.[83] But soap and water is more effective than alcohol-based hand rubs for reducing H1N1 influenza A virus[84] and Clostridium difficile spores from hands.[85]
Interventions to improve hand hygiene in healthcare settings can involve education for staff on hand washing, increasing the availability of alcohol-based hand rub, and written and verbal reminders to staff.[86] There is a need for more research into which of these interventions are most effective in different healthcare settings.[86]
Developing countries
In developing countries, hand washing with soap is recognized as a cost-effective, essential tool for achieving good health, and even good nutrition.[32] However, a lack of reliable water supply, soap or hand washing facilities in people's homes, at schools and the workplace make it a challenge to achieve universal hand washing behaviors. For example, in most of rural Africa hand washing taps close to every private or public toilet are scarce, even though cheap options exist to build hand washing stations.[60] However, low hand washing rates can also be the result of engrained habits rather than due to a lack of soap or water.[88]
Hand washing at a global level has its own indicator within Sustainable Development Goal 6, Target 6.2 which states "By 2030, achieve access to adequate and equitable sanitation and hygiene for all and end open defecation, paying special attention to the needs of women and girls and those in vulnerable situations.[87] The corresponding Indicator 6.2.1 is formulated as follows: "Proportion of population using (a) safely managed sanitation services and (b) a hand-washing facility with soap and water" (see map to the right with data worldwide from 2017)."
Promotion campaigns
The promotion and advocacy of hand washing with soap can influence policy decisions, raise awareness about the benefits of hand washing and lead to long-term behavior change of the population.[89] For this to work effectively, monitoring and evaluation are necessary. A systematic review of 70 studies found that community-based approaches are effective at increasing hand washing in LMICs, while social marketing campaigns are less effective.[90]

One example for hand washing promotion in schools is the "Three Star Approach" by UNICEF that encourages schools to take simple, inexpensive steps to ensure that students wash their hands with soap, among other hygienic requirements. When minimum standards are achieved, schools can move from one to ultimately three stars.[91] Building hand washing stations can be a part of hand washing promotion campaigns that are carried out to reduce diseases and child mortality.
Global Handwashing Day is another example of an awareness-raising campaign that is trying to achieve behavior change.[92]
As a result of the ongoing COVID-19 pandemic, UNICEF promoted the adoption of a hand washing emoji.[93]
Designing hand washing facilities that encourage use can use the following aspects:[62]
- Nudges, cues and reminders
- Hand washing facilities should be placed at convenient locations to encourage people to use them regularly and at the right times; they should be attractive and well maintained.
Cost effectiveness
.jpg.webp)
Few studies have considered the overall cost effectiveness of hand washing in developing countries in relationship to DALYs averted. However, one review suggests that promoting hand washing with soap is significantly more cost-effective than other water and sanitation interventions.[94]
| Intervention | Costs (US$/DALY) |
|---|---|
| Hand-pump or standpost | 94 |
| House water connection | 223 |
| Water sector regulation | 47 |
| Basic sanitation – construction and promotion | ≤270 |
| Sanitation promotion only | 11.2 |
| Hygiene promotion | 3.4 |
History

The importance of hand washing for human health – particularly for people in vulnerable circumstances like mothers who had just given birth or wounded soldiers in hospitals – was first[95] recognized in the mid 19th century by two pioneers of hand hygiene: the Hungarian physician Ignaz Semmelweis who worked in Vienna, Austria and Florence Nightingale, the English "founder of modern nursing".[96] At that time most people still believed that infections were caused by foul odors called miasmas.
In the 1980s, foodborne outbreaks and healthcare-associated infections led the United States Centers for Disease Control and Prevention to more actively promote hand hygiene as an important way to prevent the spread of infection. The outbreak of swine flu in 2009 and the COVID-19 pandemic in 2020 led to increased awareness in many countries of the importance of washing hands with soap to protect oneself from such infectious diseases.[16] For example, posters with "correct hand washing techniques" were hung up next to hand washing sinks in public toilets and in the toilets of office buildings and airports in Germany.
Society and culture
Moral aspects
The phrase "washing one's hands of" something, means declaring one's unwillingness to take responsibility for the thing or share complicity in it. It originates from the bible passage in Matthew where Pontius Pilate washed his hands of the decision to crucify Jesus Christ, but has become a phrase with a much wider usage in some English communities.
In Shakespeare's Macbeth, Lady Macbeth begins to compulsively wash her hands in an attempt to cleanse an imagined stain, representing her guilty conscience regarding crimes she had committed and induced her husband to commit.
It has also been found that people, after having recalled or contemplated unethical acts, tend to wash hands more often than others, and tend to value hand washing equipment more. Furthermore, those who are allowed to wash their hands after such a contemplation are less likely to engage in other "cleansing" compensatory actions, such as volunteering.[97][98]
Religion

Religions prescribe hand washing for both hygienic and symbolic purposes.[99]
Symbolic hand washing, using water but no soap to wash hands, is a part of ritual hand washing featured in many religions, including the Baháʼí Faith, Hinduism, tevilah and netilat yadayim in Judaism, Cantharus and Lavabo in Christianity,[100][101][102] and Wudhu in Islam.[99] Religions also prescribe hygienic hand washing, especially after certain actions. Hinduism, Judaism, Christianity,[100][101][103] and Islam mandate washing of hands after using the toilet. Hinduism, Buddhism, Sikhism, Judaism, certain denominations of Christianity,[104] and Islam mandate washing of hands before and after every meal.[99]
See also
- Antibiotic resistance
- Didier Pittet, an infectious diseases expert
- Food safety
- Bactericide
- Global Handwashing Day
- Nosocomial infection
- Occupational biosafety
- Public health
- Patient safety
- Rubbing alcohol
- Virucide
References
- "Show Me the Science – How to Wash Your Hands". www.cdc.gov. 4 March 2020. Retrieved 6 March 2020.
- Huang C, Ma W, Stack S (August 2012). "The hygienic efficacy of different hand-drying methods: a review of the evidence". Mayo Clinic Proceedings. 87 (8): 791–8. doi:10.1016/j.mayocp.2012.02.019. PMC 3538484. PMID 22656243.
- "Coronavirus Disease 2019 (COVID-19)". Centers for Disease Control and Prevention. 11 February 2020.
- Centers for Disease Control (2 April 2020). "When and How to Wash Your Hands". cdc.gov.
- Bloomfield, Sally F.; Aiello, Allison E.; Cookson, Barry; O'Boyle, Carol; Larson, Elaine L. (December 2007). "The effectiveness of hand hygiene procedures in reducing the risks of infections in home and community settings including hand washing and alcohol-based hand sanitizers". American Journal of Infection Control. 35 (10): S27–S64. doi:10.1016/j.ajic.2007.07.001. PMC 7115270.
- "WHO: How to handwash? With soap and water". YouTube.
- "Hand Hygiene: How, Why & When" (PDF). World Health Organization.
- "UNICEF Malawi". www.unicef.org. Retrieved 5 January 2020.
- Paludan-Müller AS, Boesen K, Klerings I, Jørgensen KJ, Munkholm K (April 2020). "Hand cleaning with ash for reducing the spread of viral and bacterial infections: a rapid review". The Cochrane Database of Systematic Reviews. 4 (7): CD013597. doi:10.1002/14651858.cd013597. PMC 7192094. PMID 32343408.
- de Almeida e Borges LF, Silva BL, Gontijo Filho PP (August 2007). "Hand washing: changes in the skin flora". American Journal of Infection Control. 35 (6): 417–20. doi:10.1016/j.ajic.2006.07.012. PMID 17660014.
- Wilkinson JM, Treas LA (2011). Fundamentals of Nursing (2nd ed.). Philadelphia: F.A. Davis Co.
- "When and How to Wash Your Hands". www.cdc.gov. 4 December 2019. Retrieved 6 March 2020.
- "When and How to Wash Your Hands | Handwashing | CDC". www.cdc.gov. 4 December 2019. Retrieved 7 March 2020.
- "The right way to wash your hands". Mayo Clinic. Retrieved 7 March 2020.
- Cowling BJ, Chan KH, Fang VJ, Cheng CK, Fung RO, Wai W, et al. (October 2009). "Facemasks and hand hygiene to prevent influenza transmission in households: a cluster randomized trial". Annals of Internal Medicine. 151 (7): 437–46. doi:10.7326/0003-4819-151-7-200910060-00142. PMID 19652172.
- "Getting your workplace ready for COVID-19" (PDF). World Health Organization. 27 February 2020. Retrieved 27 March 2020.
- Luby SP, Agboatwalla M, Painter J, Altaf A, Billhimer W, Keswick B, Hoekstra RM (April 2006). "Combining drinking water treatment and hand washing for diarrhoea prevention, a cluster randomised controlled trial". Tropical Medicine & International Health. 11 (4): 479–89. doi:10.1111/j.1365-3156.2006.01592.x. PMID 16553931. S2CID 7747732.
- Scott B, Curtis V, Rabie T. "Protecting Children from Diarrhoea and Acute Respiratory Infections: The Role of Hand Washing Promotion in Water and Sanitation Programmes" (PDF). Archived from the original (PDF) on 28 June 2009. Retrieved 21 May 2009.
- Rhee V, Mullany LC, Khatry SK, Katz J, LeClerq SC, Darmstadt GL, Tielsch JM (July 2008). "Maternal and birth attendant hand washing and neonatal mortality in southern Nepal". Archives of Pediatrics & Adolescent Medicine. 162 (7): 603–8. doi:10.1001/archpedi.162.7.603. PMC 2587156. PMID 18606930.
- Dangour AD, Watson L, Cumming O, Boisson S, Che Y, Velleman Y, et al. (August 2013). "Interventions to improve water quality and supply, sanitation and hygiene practices, and their effects on the nutritional status of children" (PDF). The Cochrane Database of Systematic Reviews (8): CD009382. doi:10.1002/14651858.CD009382.pub2. PMID 23904195. S2CID 205199671.
- Curtis V, Cairncross S (May 2003). "Effect of washing hands with soap on diarrhoea risk in the community: a systematic review". The Lancet. Infectious Diseases. 3 (5): 275–81. doi:10.1016/S1473-3099(03)00606-6. PMID 12726975.
- Ejemot RI, Ehiri JE, Meremikwu MM, Critchley JA (2009). "Cochrane review: Hand washing for preventing diarrhoea". Evidence-Based Child Health: A Cochrane Review Journal. 4 (2): 893–939. doi:10.1002/ebch.373. ISSN 1557-6272.
- Cairncross S, Hunt C, Boisson S, Bostoen K, Curtis V, Fung IC, Schmidt WP (April 2010). "Water, sanitation and hygiene for the prevention of diarrhoea". International Journal of Epidemiology. 39 Suppl 1 (Supplement 1): i193-205. doi:10.1093/ije/dyq035. PMC 2845874. PMID 20348121.
- The State of the World's Children 2008. UNICEF. November 2008. ISBN 978-92-806-4191-2.
- "Impetigo". NHS. 19 October 2017. Retrieved 11 March 2020.
- "Too-Clean Hands Can Lead to Eczema". EverydayHealth.com. Retrieved 24 January 2020.
- "JMP handwashing dataset". Archived from the original on 2 April 2016. Retrieved 20 March 2017.
WHO/UNICEF Joint Monitoring Programme (JMP) for Water Supply and Sanitation
- BreakingWeb. "Les Français et le savonnage des mains après être allé aux toilettes". BVA Group (in French). Retrieved 9 February 2020.
- Abdi & Gautam, R. & O.P, Approaches to promoting behaviour-change around handwashing-with-soap Archived 21 March 2017 at the Wayback Machine
- "How to Trigger for Handwashing with Soap". Sanitation Learning Hub. Retrieved 13 December 2021.
- UNICEF, GIZ (2016). Scaling up group handwashing in schools – Compendium of group washing facilities across the globe. New York; Eschborn, Germany
- UNICEF (2012) Raising Even More Clean Hands: Advancing Health, Learning and Equity through WASH in Schools Archived 4 March 2016 at the Wayback Machine, Joint Call to Action
- School Community Manual – Indonesia (formerly Manual for teachers), Fit for School. GIZ Fit for School, Philippines. 2014. ISBN 978-3-95645-250-5.
- "Double hand washing with a fingernail brush. HACCP – HITM: food science safety and HACCP training and certification provider". 2 July 2019. Archived from the original on 2 July 2019. Retrieved 8 April 2020.
- Tumosa CS (1 September 2001). "A brief history of aluminum stearate as a component of paint". cool.conservation-us.org. Archived from the original on 18 March 2017. Retrieved 5 April 2017.
- McBride ME (August 1984). "Microbial flora of in-use soap products". Applied and Environmental Microbiology. 48 (2): 338–41. Bibcode:1984ApEnM..48..338M. doi:10.1128/AEM.48.2.338-341.1984. PMC 241514. PMID 6486782.
- Heinze JE, Yackovich F (August 1988). "Washing with contaminated bar soap is unlikely to transfer bacteria". Epidemiology and Infection. 101 (1): 135–42. doi:10.1017/s0950268800029290. PMC 2249330. PMID 3402545.
- "Infection Control: Frequently Asked Questions – Hand Hygiene". Centers for Disease Control and Prevention. Retrieved 30 September 2016.
- Weber DJ, Rutala WA (October 2006). "Use of germicides in the home and the healthcare setting: is there a relationship between germicide use and antibiotic resistance?". Infection Control and Hospital Epidemiology. 27 (10): 1107–19. doi:10.1086/507964. PMID 17006819. S2CID 20734025.
- US5942478A, "Microbicidal and sanitizing soap compositions", issued 1997-09-04
- "Plain soap as effective as antibacterial but without the risk". Retrieved 17 August 2007.
- Montville R, Schaffner DW (November 2011). "A meta-analysis of the published literature on the effectiveness of antimicrobial soaps". Journal of Food Protection. 74 (11): 1875–82. doi:10.4315/0362-028X.JFP-11-122. PMID 22054188.
- "Antibacterial Soap Has Poor Killing Power". Scientific American. 24 September 2015. Retrieved 14 April 2020.
- World Health Organization. "WHO Guidelines on Hand Hygiene in Health Care (Advanced Draft)" (PDF). Retrieved 21 July 2008.
- Michaels B, Gangar V, Schultz A, Arenas M, Curiale M, Ayers T, Paulson D (2002). "Water temperature as a factor in handwashing efficacy". Food Service Technology. 2 (3): 139–49. doi:10.1046/j.1471-5740.2002.00043.x.
- Laestadius JG, Dimberg L (April 2005). "Hot water for handwashing--where is the proof?". Journal of Occupational and Environmental Medicine. 47 (4): 434–5. doi:10.1097/01.jom.0000158737.06755.15. PMID 15824636. S2CID 37287489.
- Carrico AR, Spoden M, Wallston KA, Vandenbergh MP (July 2013). "The Environmental Cost of Misinformation: Why the Recommendation to Use Elevated Temperatures for Handwashing is Problematic". International Journal of Consumer Studies. 37 (4): 433–441. doi:10.1111/ijcs.12012. PMC 3692566. PMID 23814480.
- Gold NA, Avva U (2021). "Alcohol Sanitizer". StatPearls [Internet]. PMID 30020626. Retrieved 12 March 2020.
- Menegueti MG, Laus AM, Ciol MA, Auxiliadora-Martins M, Basile-Filho A, Gir E, et al. (24 June 2019). "Glycerol content within the WHO ethanol-based handrub formulation: balancing tolerability with antimicrobial efficacy". Antimicrobial Resistance and Infection Control. 8 (1): 109. doi:10.1186/s13756-019-0553-z. PMC 6591802. PMID 31285821.
- National Center for Biotechnology Information (2009). WHO-recommended handrub formulations. World Health Organization.
- "Preventing Norovirus Infection". www.cdc.gov. 9 March 2018. Retrieved 17 May 2018.
- "Handwashing: Clean Hands Save Lives". Center for Disease Control and Prevention. 16 March 2020. Retrieved 26 July 2012.
- Butz AM, Laughon BE, Gullette DL, Larson EL (April 1990). "Alcohol-impregnated wipes as an alternative in hand hygiene". American Journal of Infection Control. 18 (2): 70–6. doi:10.1016/0196-6553(90)90084-6. PMID 2337257.
- "When and How to Wash Your Hands". CDC. 10 August 2021.
- "Water Sanitation Health. How can personal hygiene be maintained in difficult circumstances?". WHO. 2014. Archived from the original on 14 February 2005. Retrieved 12 March 2020.
- Baker, K.K.; Dil Farzana, F.; Ferdous, F.; Ahmed, S.; Kumar Das, S.; Faruque, A.S.G.; Nasrin, D.; Kotloff, K.L.; Nataro, J.P.; Kolappaswamy, K.; Levine, M.M. (28 April 2014). "Association between Moderate-to-Severe Diarrhea in Young Children in the Global Enteric Multi center Study (GEMS) and Types of Hand washing Materials Used by Caretakers in Mirzapur, Bangladesh". American Journal of Tropical Medicine and Hygiene. 91 (1): 181–89. doi:10.4269/ajtmh.13-0509. PMC 4080560. PMID 24778193.
- Bloomfield SF, Nath KJ (October 2009). Use of ash and mud for handwashing in low income communities. International Scientific Forum on Home Hygiene (IFH). Somerset, England.
- Howard G, Bogh C (2002). "Chapter 8 Personal, domestic and community hygiene". Healthy villages: a guide for communities and community health workers. World Health Organization. ISBN 978-92-4-154553-2.
- "The Hygiene Improvement Project (HIP) – Tippy-Tap: A simple low-cost technology for handwashing when water is scarce". USAID. Archived from the original on 25 October 2014. Retrieved 30 September 2015.
- Morgan P (2011). "Hand washing devices – How to make and use". Zimbabwe: Aquamor Pvt Ltd.
- Rao A (11 September 2014). "When Low-Tech Solutions Win". Slate. ISSN 1091-2339.
- Coultas, M. and Iyer, R. with Myers, J. (2020). Handwashing Compendium for Low Resource Settings: A Living Document. Edition 1, The Sanitation Learning Hub, Brighton: IDS, ISBN 978-1-78118-638-1 (alternative URL)
- Carni Y (10 July 2019). "By Gamifying Hand Washing, Soapy Might Just Save Civilization". Forbes.
- "How Swiss scale-up Smixin battles the spread of infectious disease worldwide". GGBa Invest Western Switzerland. 12 May 2020.
- Sun DD (21 July 2020). "New safety tool at SEA Airport scans restaurant employee hands to ensure cleanliness". KIRO 7 News.
- Pick A (3 September 2020). "This Startup Wants to Fight Coronavirus With Soap and Water". Calcalist.
- Stahl J (4 April 2020). "Interest in Israeli Smart Hand-Washing Device Surges with Coronavirus". The Christian Broadcasting Network, Inc.
- Joe (7 April 2020). "Soapy Washes Your Hands Clean Of Corona!". JLM-BioCity.
- Reynolds KA, Sexton JD, Norman A, McClelland DJ (January 2021). "Comparison of electric hand dryers and paper towels for hand hygiene: a critical review of the literature". Journal of Applied Microbiology. 130 (1): 25–39. doi:10.1111/jam.14796. PMC 7818469. PMID 32794646.
- Redway K, Fawdar S (November 2008). A comparative study of three different hand drying methods: paper towel, warm air dryer, jet air dryer (PDF) (Report). The School of Biosciences, University of Westminster London.
- Davis R (2015). "The Doctor Who Championed Hand-Washing And Briefly Saved Lives". NPR.
- Boyce JM (October 2011). "Measuring healthcare worker hand hygiene activity: current practices and emerging technologies". Infection Control and Hospital Epidemiology. 32 (10): 1016–28. doi:10.1086/662015. PMID 21931253. S2CID 19428439.
- Swoboda SM, Earsing K, Strauss K, Lane S, Lipsett PA (February 2004). "Electronic monitoring and voice prompts improve hand hygiene and decrease nosocomial infections in an intermediate care unit". Critical Care Medicine. 32 (2): 358–63. doi:10.1097/01.CCM.0000108866.48795.0F. PMID 14758148. S2CID 9817602.
- Larson EL (August 1995). "APIC guideline for handwashing and hand antisepsis in health care settings". American Journal of Infection Control. 23 (4): 251–69. doi:10.1016/0196-6553(95)90070-5. PMID 7503437.
- "Surgical Handrubbing Technique" (PDF). World Health Organization. Archived from the original (PDF) on 29 April 2016.
- Goldmann D (July 2006). "System failure versus personal accountability--the case for clean hands". The New England Journal of Medicine. 355 (2): 121–3. doi:10.1056/NEJMp068118. PMID 16837675.
- Pronovost P, Needham D, Berenholtz S, Sinopoli D, Chu H, Cosgrove S, et al. (December 2006). "An intervention to decrease catheter-related bloodstream infections in the ICU". The New England Journal of Medicine. 355 (26): 2725–32. doi:10.1056/NEJMoa061115. PMID 17192537.
- World Health Organization. "How to Handrub & How to Handwash" (PDF). Retrieved 21 July 2008.
- Whitby M, Pessoa-Silva CL, McLaws ML, Allegranzi B, Sax H, Larson E, et al. (January 2007). "Behavioural considerations for hand hygiene practices: the basic building blocks". The Journal of Hospital Infection. 65 (1): 1–8. doi:10.1016/j.jhin.2006.09.026. PMID 17145101.
- WHO Guidelines on Hand Hygiene in Health Care
- Beggs CB, Shepherd SJ, Kerr KG (September 2008). "Increasing the frequency of hand washing by healthcare workers does not lead to commensurate reductions in staphylococcal infection in a hospital ward". BMC Infectious Diseases. 8: 114. doi:10.1186/1471-2334-8-114. PMC 2553083. PMID 18764942.
- Fischler GE, Fuls JL, Dail EW, Duran MH, Rodgers ND, Waggoner AL (December 2007). "Effect of hand wash agents on controlling the transmission of pathogenic bacteria from hands to food". Journal of Food Protection. 70 (12): 2873–7. doi:10.4315/0362-028X-70.12.2873. PMID 18095447.
- Girou E, Loyeau S, Legrand P, Oppein F, Brun-Buisson C (August 2002). "Efficacy of handrubbing with alcohol based solution versus standard handwashing with antiseptic soap: randomised clinical trial". BMJ. 325 (7360): 362. doi:10.1136/bmj.325.7360.362. PMC 117885. PMID 12183307.
- Grayson ML, Melvani S, Druce J, Barr IG, Ballard SA, Johnson PD, et al. (February 2009). "Efficacy of soap and water and alcohol-based hand-rub preparations against live H1N1 influenza virus on the hands of human volunteers". Clinical Infectious Diseases. 48 (3): 285–91. doi:10.1086/595845. PMID 19115974.
- Jabbar U, Leischner J, Kasper D, Gerber R, Sambol SP, Parada JP, et al. (June 2010). "Effectiveness of alcohol-based hand rubs for removal of Clostridium difficile spores from hands". Infection Control and Hospital Epidemiology. 31 (6): 565–70. doi:10.1086/652772. PMID 20429659. S2CID 205994880.
- Gould DJ, Moralejo D, Drey N, Chudleigh JH, Taljaard M (September 2017). "Interventions to improve hand hygiene compliance in patient care". The Cochrane Database of Systematic Reviews. 2017 (9): CD005186. doi:10.1002/14651858.CD005186.pub4. PMC 6483670. PMID 28862335.
- Ritchie, Roser, Mispy, Ortiz-Ospina (2018) "Measuring progress towards the Sustainable Development Goals." (SDG 6) SDG-Tracker.org, website
- Curtis V, Scott B, Cardosi J (2000). "The Handwashing Handbook – A guide for developing a hygiene promotion program to increase handwashing with soap". The International Bank for Reconstruction and Development/The World Bank.
- Vujcic J, Ram PK (2013). Handwashing Promotion – Monitoring and Evaluation Module. New York: UNICEF.
- De Buck E, Van Remoortel H, Hannes K, Govender T, Naidoo S, Avau B, Veegaete AJ, Musekiwa A, Lutje V, Cargo M, Mosler HJ (19 May 2017). "Approaches to promote handwashing and sanitation behaviour change in low‐ and middle‐income countries: a mixed method systematic review". Campbell Systematic Reviews. 13 (1): 1–447. doi:10.4073/csr.2017.7.
- UNICEF, GIZ (2013). "The Three Star Approach for WASH in Schools". Field Guide. Eschborn, Germany: United Nations Children's Fund and Deutsche Gesellschaft für Internationale Zusammenarbeit (GIZ).
- PPPHW (2014). Global Handwashing Day Planner's Guide (3rd ed.). FHI 360 for the Global Public-Private Partnership for Handwashing with Soap.
- "What about a handwashing emoji??!". www.unicef.org. Retrieved 13 March 2020.
- Cairncross S, Valdmanis V (2006). "41: Water Supply, Sanitation, and Hygiene Promotion" (PDF). In Jamison DT, Breman JG, Measham AR, Alleyne G, Claeson M, Evans DB, et al. (eds.). Disease Control Priorities in Developing Countries (Second ed.). World Bank Group. pp. 771–92. doi:10.1596/978-0-8213-6179-5. ISBN 978-0-8213-6179-5. PMID 21250333.
- Semmelweisig, Ignaz (1861). Die Aetiologie, der Begriff und die Prophylaxis des Kindbettfiebers.
- "The Global Public-Private Partnership for Handwashing". globalhandwashing.org. 19 March 2015. Retrieved 18 April 2015.
- Carey B (12 September 2006). "Lady Macbeth Not Alone in Her Quest for Spotlessness". The New York Times.
- Zhong CB, Liljenquist K (September 2006). "Washing away your sins: threatened morality and physical cleansing". Science. 313 (5792): 1451–2. Bibcode:2006Sci...313.1451Z. CiteSeerX 10.1.1.181.571. doi:10.1126/science.1130726. PMID 16960010. S2CID 33103635.
Wheatley T, Haidt J (October 2005). "Hypnotic disgust makes moral judgments more severe". Psychological Science. 16 (10): 780–4. doi:10.1111/j.1467-9280.2005.01614.x. PMID 16181440. S2CID 14114448. - "Religious and cultural aspects of hand hygiene". WHO Guidelines on Hand Hygiene in Health Care: First Global Patient Safety Challenge Clean Care Is Safer Care. World Health Organization. 2009.
- Bradley I (2 November 2012). Water: A Spiritual History. Bloomsbury Publishing. ISBN 978-1-4411-6767-5.
It was probably out of the Jewish rite that the practice developed among early Christians, especially in the east, of washing their hands and feet before going into church. Early Christian basilicas had a fountain for ablutions, known as cantharus or phiala, and usually placed in the centre of the atrium. They are still found in some Eastern Orthodox churches, notably at the monastery of Laura at Mount Athos, where the phiala is an imposing structure in front of the entrance covered by a dome resting on eight pillars. In several Orthodox churches today worshippers take off heir shoes and wash their feet before entering the church just as Muslims do before going into a mosque.
- Bingham J (1840). The antiquities of the Christian Church. W. Straker. p. 396.
In the middle of which stood a Fountain for washing as they entered into the Church, called Cantharus and Phiala in some authors. It is further to be noted, that in the middle of the atrium, there was commonly a fountain, or a cistern of water, for people to wash their hands and face, before they went into the church.
- Z. Wahrman, Miryam (2016). The Hand Book: Surviving in a Germ-Filled World. University Press of New England. p. 46-48. ISBN 978-1-61168-955-6.
Water plays a role in other Christian rituals as well. ... In the early days of Christianity, two to three centuries after Christ, the lavabo (Latin for "I wash myself"), a ritual handwashing vessel and bowl, was introduced as part of Church service.
- Pedersen KS (1999). "Is the Church of Ethiopia a Judaic Church?" (PDF). Warszawskie Studia Teologiczne. 12 (2): 213–16.
- Pringle P (2009). Inspired to Pray: The Art of Seeking God. Gospel Light Publications. p. 90. ISBN 978-0-8307-4811-2.
External links
- Hand Hygiene: Why, How & When? (PDF from the World Health Organization)
- Centers for Disease Control on hand hygiene in healthcare settings
- Global Public-Private Partnership for Hand washing
- Photos of low-cost hand washing installations in developing countries (collected by Sustainable Sanitation Alliance)
- OCD and Hand Washing
- WHO: How to handwash with soap and water (video)

